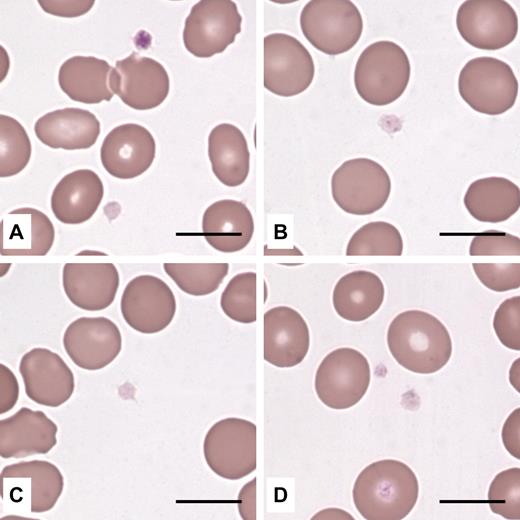
Figure 1. Platelets from THC2 patients have reduced azurophilic granule content. Platelets in peripheral blood smears (May-Grünwald-Giemsa staining) from 4 different probands were normal in size and appeared pale because of reduced content (B,D) or complete absence (A,C) of azurophilic granules. (A) One platelet had a normal granule content. Scale bars represent 10 μm. Images were acquired by an Axioscope 2 Plus microscope (Carl Zeiss) using a 100×/1.30 (oil-immersion) Plan Neofluar objective (Carl Zeiss). The Axiocam MRc5 camera (Carl Zeiss) and Axiovision 4.6 software (Carl Zeiss) were used to capture and process images.

Abstract
Until recently, thrombocytopenia 2 (THC2) was considered an exceedingly rare form of autosomal dominant thrombocytopenia and only 2 families were known. However, we recently identified mutations in the 5′-untranslated region of the ANKRD26 gene in 9 THC2 families. Here we report on 12 additional pedigrees with ANKRD26 mutations, 6 of which are new. Because THC2 affected 21 of the 210 families in our database, it has to be considered one of the less rare forms of inherited thrombocytopenia. Analysis of all 21 families with ANKRD26 mutations identified to date revealed that thrombocytopenia and bleeding tendency were usually mild. Nearly all patients had no platelet macrocytosis, and this characteristic distinguishes THC2 from most other forms of inherited thrombocytopenia. In the majority of cases, platelets were deficient in glycoprotein Ia and α-granules, whereas in vitro platelet aggregation was normal. Bone marrow examination and serum thrombopoietin levels suggested that thrombocytopenia was derived from dysmegakaryopoiesis. Unexplained high values of hemoglobin and leukocytes were observed in a few cases. An unexpected finding that warrants further investigation was a high incidence of acute leukemia. Given the scarcity of distinctive characteristics, the ANKRD26-related thrombocytopenia has to be taken into consideration in the differential diagnosis of isolated thrombocytopenias.
Introduction
Making a definitive diagnosis in patients with inherited thrombocytopenia is important because different forms differ with respect to prognosis and treatment. For example, congenital amegakaryocytic thrombocytopenia always presents with severe thrombocytopenia at birth and rapidly progresses to trilineage bone marrow failure that benefits from bone marrow transplantation.1 Thrombocytopenia is severe at birth also in “thrombocytopenia with absent radii,” but platelet count improves over the first year of life and eventually approaches normal levels in adult life.2 Thus, only supportive treatment is usually required. Recently, thrombopoietin (TPO) mimetics were shown to increase platelet count in MYH9-related disorders,3 opening up new therapeutic possibilities for these illnesses. Some inherited thrombocytopenias, such as familial platelet disorder with propensity for myeloid malignancy, significantly increase the risk of leukemia,4 whereas others, such as MYH9-related disorders,5 expose to the risk of extrahematologic defects that may benefit from early recognition and appropriate treatment.6 Thus, a careful and targeted follow-up is mandatory for these patients.
Unfortunately, a common experience for all who care for subjects with hereditary thrombocytopenias is that making a definite diagnosis is not possible in several patients because their disorders have never been described. An analysis of a series of 46 consecutive patients revealed that these “new” illnesses affect nearly 40% of patients.7 Because prognosis and treatment remain poorly defined in a large portion of cases, the identification and characterization of “new” forms are important objectives in present research.
Thrombocytopenia 2 (THC2, MIM 188000) is an autosomal dominant form of thrombocytopenia that, until recently, was identified in only 2 families: one in Italy8 and the other in the United States.9 The THC2 locus was mapped to chromosome 10p11.1-p12 in both families, and 2 missense mutations in the MASTL (MIM 608221) and ACBD5 genes were subsequently identified as the causative defects in the North American family10 and Italian family,11 respectively. However, we recently showed that 6 different heterozygous single nucleotide substitutions in a short stretch of the 5′-untranslated region (5′-UTR) of ANKRD26 (MIM 610855), a gene within the THC2 locus, were responsible for thrombocytopenia in 9 pedigrees.12 Notably, the previously identified Italian family with the ACBD5 substitution also had this type of mutation.
Here we present the results of a systematic screening of 105 unrelated subjects with inherited thrombocytopenias of unknown origin that allowed us to recognize 12 additional families with mutations in the same ANKRD26 region and to identify 6 novel mutations. We also describe the clinical and laboratory pictures that emerged from the study of all 78 patients with ANKRD26 mutations identified thus far, and discuss the unexpected finding of high frequency of acute leukemia in affected pedigrees.
Methods
Patients
We enrolled 105 unrelated patients with inherited thrombocytopenias that were being observed at the Istituto di Ricovero e Cura a Carattere Scientifico Policlinico San Matteo Foundation of Pavia and at the Department of Pediatrics of the Second University of Naples. All of them had no definite diagnosis because they did not fit the criteria for any known disorder. Whenever ANKRD26 mutations were identified, the proband's available relatives were studied. We also included the patients (35 from 9 families) already known to have ANKRD26 mutations, as recently published.12
In addition, we investigated 37 patients with autoimmune thrombocytopenia (ITP). This diagnosis was made according to the guidelines recently released by a panel of experts13 and was confirmed by the evaluation of response to therapy and subsequent clinical evolution.
Bleeding tendency was measured by the World Health Organization bleeding scale: grade 0 indicates no bleeding; grade 1, petechiae; grade 2, mild blood loss; grade 3, gross blood loss; and grade 4, debilitating blood loss. Physicians participating in the study made this evaluation during patient interviews.
The institutional review boards of the Istituto di Ricovero e Cura a Carattere Scientifico Policlinico San Matteo Foundation of Pavia and the Department of Pediatrics of the Second University of Naples approved the study. All subjects provided written informed consent in accordance with the Declaration of Helsinki.
Mutation screening
The 5′-UTR of the ANKRD26 gene was screened for mutations using genomic DNA extracted from peripheral blood. Mutational analysis was performed by polymerase chain reaction (PCR) amplification using oligo 1F (5′-CATGGAGCACACTTGACCAC-3′) and 1R (5′-TACTCCAGTGGCACTCAGTC-3′). PCR was carried out in a total volume of 25 μL with 25 ng of genomic DNA, 10μM of each primer, 2.5μM dNTPs, 1.5mM MgCl2, and 1.25 U of AmpliTaq Gold DNA polymerase (Applied Biosystems) and 2.5 μL of the corresponding 10× PCR buffer. After an initial denaturation step at 96°C for 12 minutes, amplification was performed for 30 cycles (denaturation at 96°C for 30 seconds, annealing at 62°C for 45 seconds, and extension at 72°C for 50 seconds). PCR products were bidirectionally sequenced using the ABI PRISM BigDye Terminator Cycle Sequencing Ready Reaction Kit and ABI310 Genetic Analyzer (Applied Biosystems).
Blood cell counts and platelet size
Blood cell counts and mean platelet volume were evaluated by electronic counters in ethylenediaminetetraacetic acid anticoagulated blood samples within 2 hours after sampling. Because electronic instruments are known to be inaccurate in patients with extreme degrees of platelet macrocytosis or microcytosis,14 in all cases these conditions were excluded by direct examination of peripheral blood films.
Platelet α-granules
According to a previously reported method,15 peripheral blood smears were stained with the P12 antibody (Sigma-Aldrich) against the α-granules secretory proteins thrombospondin-1 (TSP1), and platelets were identified by labeling for F-actin (AlexaFluor-488-conjugated phalloidin, Invitrogen). We evaluated 300 platelets in each specimen and measured the percentage of platelets with less than or equal to 5 TSP1+ granules. This cut-off was chosen to distinguish platelets that, although not completely negative, presented a very marked reduction in α-granules. Results were compared with those obtained in the same sets of experiments for smears from 30 healthy subjects. In control subjects, the percentage of platelets with more than 5 TSP1+ granules ranged from 94% to 99%.
Platelet flow cytometry
Surface expression of platelet glycoproteins (GPs) was investigated in platelet-rich plasma by flow cytometry with an Epics XL flow cytometer (Coulter Corporation) as previously reported.15 The following monoclonal antibodies were used: SZ21 (Immunotech) that recognizes GPIIIa (CD61), P2 (Immunotech) recognizing GPIIb in the intact complex with GPIIIa (CD41), SZ1 and SZ2 (Immunotech) against GPIX (CD42a) when correctly complexed with GPIbα and GPIbα (CD42b), Gi9 (Immunotech) against GPIa (CD49b), and 4B7R (Santa Cruz Biotechnologies) against GPIIa (CD29); MO2 (Coulter Corporation) was used as a negative control. Fluorescein isothiocyanate-conjugated goat antimouse IgG was purchased from Coulter Corporation.
Because platelet expression of GPIa on platelets varies among normal subjects depending on 3 different haplotypes of the GPIa gene (ITGA2) defined by 4 polymorphisms,16 the control for each patient was chosen to match his ITGA2 genotype. To this aim, these polymorphisms were determined in patients and controls as previously described.15
Platelet aggregation
Blood was collected in 3.8% (weight/volume) sodium citrate (blood-anticoagulant ratio 9:1), and platelet aggregation was evaluated in platelet-rich plasma by the densitometric method of Born as previously reported.15 The analysis was performed only in patients from whom platelet-rich plasma with at least 100 × 109 platelets/L were obtained. The following platelet agonists were used: collagen (4 and 20 μg/mL; Mascia Brunelli), and adenosine diphosphate (5 and 20mM) and ristocetin (1.5 mg/mL), both from Sigma-Aldrich. The extent of platelet aggregation was measured 5 minutes after the addition of stimulating agents, and results obtained in patients were compared with the normal ranges in our laboratory.
Serum TPO
Serum TPO levels were determined by a commercially available enzyme-linked immunosorbent assay (Quantikine Human TPO Immunoassay, R&D Systems) according to the manufacturer's instructions. By this assay, TPO serum concentrations can be directly measured when in the range of 7 to 2000 pg/mL. When required by very high TPO concentration, serum was appropriately diluted. For the purposes of this study, a value of 6.9 pg/mL was assigned to the samples with a TPO concentration below the minimum detectable level.
Statistical analysis
Continuous data are presented as mean, SD, and range, categorical variables as counts and percentages. Laboratory parameters were compared with the mean value of the (reference) healthy population by the one-sample Student t test, as well as to the upper or lower reference limit (if significantly larger or smaller than the mean reference value). Incidence of hematologic malignancies (per 100 000 person-years) and its Poisson exact 95% confidence intervals are reported. Stata 11 (Stata Corporation) was used for computation.
Results
Mutation screening
Table 1 presents the 11 heterozygous single nucleotide substitutions that have been identified in the 5′-UTR region of the ANKRD26 gene in 12 of 105 investigated unrelated propositi. Six of the mutations, including c.-127A → G, c.-126T → G, c.-121A → C, c.-119C → A, c.-118C → A, and c.-113A → C, were novel mutations not detected in our previous series of THC2 patients.12 The nucleotide substitutions segregated with the disease along the pedigrees and were not reported in the 1000 genomes (www.browser.1000genomes.org) or other databases. Combining previous and present case series, 12 different mutations, all localized in a short stretch of 22 nucleotides of the 5′-UTR, were identified in 21 THC2 families. Positions −127 and −118 had 2 different substitutions: c.-127A → T or c.-127A → G and c.-118C → T or c.-118C → A. No other substitutions were identified in the 527-bp PCR product analyzed, except for the known polymorphisms, rs41299222 and rs3737056 in the 5′-UTR, and rs7897309, which leads to protein variant p.Q20R.
Of the 21 THC2 families, 17 were from Italy and the remaining from North America, Argentina, Senegal, and Spain, suggesting that THC2 is distributed worldwide.
Clinical picture
To describe the features of ANKRD26-related thrombocytopenia, we enrolled 78 affected persons from the 21 families that were genetically characterized. As usual for inherited thrombocytopenias, several patients were initially misdiagnosed with ITP, and 16 of them received immunosuppressive treatments, whereas 2 subjects were splenectomized. Except for 3 patients who reported a transient increase in the platelet count during prednisone treatment, the others did not respond to these treatments.
Spontaneous bleeding events were usually absent or mild, although a few subjects experienced life-threatening hemorrhages. According to the World Health Organization bleeding scale, 36 of 78 patients had a bleeding score of 0, whereas 17, 17, 5, and 3 subjects had bleeding scores of 1, 2, 3, and 4, respectively. More common bleeding symptoms were petechiae, ecchymosis, gum bleeding, epistaxis, and menorrhagia. One patient had 2 hemorrhagic strokes and one episode of proctorrhagia, and one child had post-traumatic brain hemorrhages. Interestingly, a patient, who previously developed hemothorax during an episode of pneumonia and underwent hysterectomy because of menorrhagia, experienced deep vein thrombosis of the leg despite severe thrombocytopenia (10 × 109 platelets/L) and no predisposing cause except for varicose veins. Twenty-six patients underwent surgery, in most cases without platelet support, and only 3 reported bleeding episodes. Thirteen women gave birth, whether vaginally or through cesarean section, and only in 3 cases there were bleeding complications.
As some forms of inherited thrombocytopenia are syndromic, we searched for diseases possibly associated with thrombocytopenia in THC2 patients. Not to exclude from this study potentially fatal diseases, we sought information on family members who died before our study. Based on clinical records, we identified another 26 family members, first- or second-grade relatives of THC2 patients, who had thrombocytopenia from an early age. Although the diagnosis of THC2 was not confirmed by molecular genetic testing, we considered them as carriers of the ANKRD26 mutation of their respective family. In this extended series of 105 patients, the only category of illness that was found to affect several subjects was that of hematologic malignancies. Seven subjects from 5 families (families 8, 9, 11, 13, and 20) had acute leukemias (5 myelogenous forms and 2 undefined forms), one patient developed chronic myelogenous leukemia (family 17), and another one chronic lymphocytic leukemia (family 12). Moreover, one patient had myelodysplastic syndrome and subsequently developed chronic lymphocytic leukemia (family 17). Furthermore, 2 other relatives of patients with ANKRD26 mutations (families 5 and 11) had acute leukemias (one myelogenous and one undefined), but we were unable to ascertain whether they were affected by THC2. Thus, at least 10 THC2 patients had hematologic malignancies and 7 presented acute leukemias. Neither acute leukemias nor other hematologic malignancies have been reported in the 78 relatives without THC2. Considering only the 105 patients with reliable information, the total observation time was 4174 years, and the incidence of all hematologic malignancies was 240 of 100 000 (95% confidence interval, 115 to 441 of 100 000), whereas that of acute leukemia was 167 of 100 000 (95% confidence interval, 67 to 345 of 100 000).
Blood cell counts and peripheral blood film examination
The thrombocytopenia of THC2 patients was moderate in most cases (Tables 1, 2), although 8 of 78 subjects had a platelet count lower than 20 × 109/L and 5 equal or lower than 10 × 109/L. Notably, one patient had a platelet count at the lower limit of the normal range, whereas 4 patients with platelet counts always lower than 50 × 109/L had their platelet count transiently increased to more than 150 × 109/L during infectious episodes (acute cholecystitis, septic arthritis, urinary tract infection, and bronchiolitis).
Hemoglobin and leukocyte values were within the normal range in the majority of patients, although values higher or lower than normal were recorded for both parameters. Although reduced hemoglobin values are not unexpected in thrombocytopenic patients because of repeated blood loss, the abnormally high levels of hemoglobin observed in 9 cases were surprising and remained without any explanation. Concerning the leukocytosis observed in 14 patients, we cannot exclude that it derived from inflammatory conditions. However, leukocytosis was reported also in the other large thrombocytopenic family linked to 10p11.1-p12 and with a mutation in the MASTL gene.9
Platelet size was normal in most cases, but some patients had a reduced mean platelet volume. Importantly, mean platelet volume was slightly increased only in one patient. Thus, THC2 resulting from ANKRD26 mutations is one of the few inherited thrombocytopenias without platelet macrocytosis.
Examination of May-Grünwald-Giemsa-stained peripheral blood films did not identify any morphologic red cell or leukocyte abnormalities. Instead, platelets appeared “pale” in many cases because of reduced azurophilic granule content (Figure 1). Immunofluorescent labeling of the α-granule protein TSP1 revealed that most patients had α-granule deficiency (Figure 2); the number of TSP1+ granules was lower than that of controls in 32 of 44 (72.7%) investigated cases. This defect did not affect all patients within the same family (data not shown), suggesting that environmental factors interacted with ANKRD26 mutations to induce the deficiency.
Platelets from THC2 patients have reduced azurophilic granule content. Platelets in peripheral blood smears (May-Grünwald-Giemsa staining) from 4 different probands were normal in size and appeared pale because of reduced content (B,D) or complete absence (A,C) of azurophilic granules. (A) One platelet had a normal granule content. Scale bars represent 10 μm. Images were acquired by an Axioscope 2 Plus microscope (Carl Zeiss) using a 100×/1.30 (oil-immersion) Plan Neofluar objective (Carl Zeiss). The Axiocam MRc5 camera (Carl Zeiss) and Axiovision 4.6 software (Carl Zeiss) were used to capture and process images.
Platelets from THC2 patients have reduced azurophilic granule content. Platelets in peripheral blood smears (May-Grünwald-Giemsa staining) from 4 different probands were normal in size and appeared pale because of reduced content (B,D) or complete absence (A,C) of azurophilic granules. (A) One platelet had a normal granule content. Scale bars represent 10 μm. Images were acquired by an Axioscope 2 Plus microscope (Carl Zeiss) using a 100×/1.30 (oil-immersion) Plan Neofluar objective (Carl Zeiss). The Axiocam MRc5 camera (Carl Zeiss) and Axiovision 4.6 software (Carl Zeiss) were used to capture and process images.
Platelets from THC2 patients have a defect in α-granule content. Peripheral blood smears were stained with the P12 antibody against the α-granule protein TSP1 (red), and platelets were identified by labeling for F-actin (green). (A-B) One platelet from a control subject with normal content in α-granules. (C-D) One representative platelet of a THC2 patient with 2 TSP1+ granules. Scale bars represent 5 μm. Images were acquired as described in Figure 1 legend using a 100×/1.30 Plan Neofluar oil-immersion objective from Carl Zeiss.
Platelets from THC2 patients have a defect in α-granule content. Peripheral blood smears were stained with the P12 antibody against the α-granule protein TSP1 (red), and platelets were identified by labeling for F-actin (green). (A-B) One platelet from a control subject with normal content in α-granules. (C-D) One representative platelet of a THC2 patient with 2 TSP1+ granules. Scale bars represent 5 μm. Images were acquired as described in Figure 1 legend using a 100×/1.30 Plan Neofluar oil-immersion objective from Carl Zeiss.
Bone marrow examination
Bone marrow smear and/or biopsy were available for 4 probands (families 4, 8, 11, and 14). Common to all samples was an increased number of megakaryocytes (Mks), which were represented at all stages of maturation, with evidence of dysmegakaryopoiesis. Dystrophic forms consisted mainly of small Mks with hypolobulated nuclei and a small amount of mature eosinophilic cytoplasm. Typical micromegakaryocytes were also present. Representative examples are provided in Figure 3.
Bone marrow from THC2 patients present an increased number of Mks and dysmegakaryopoiesis. (A-B) Bone marrow biopsy (hematoxylin and eosin staining) of a member of family 4 showed normal cellularity with an increased number of Mks (arrows). Scale bars represent 50 μm. (C-F) Bone marrow smears (May-Grünwald-Giemsa staining) from members of families 8, 11, and 14. Representative examples of small, dystrophic Mks with hypolobulated nuclei and a small amount of mature eosinophilic cytoplasm. Typical micromegakaryocytes (F) were also observed. Scale bars represent 10 μm. Images were acquired as described in Figure 1 legend using a 20×/0.50 Plan Neofluar objective (panels A-B) and a 63×/1.25 Plan Neofluar oil-immersion objective (panels C-F) from Carl Zeiss.
Bone marrow from THC2 patients present an increased number of Mks and dysmegakaryopoiesis. (A-B) Bone marrow biopsy (hematoxylin and eosin staining) of a member of family 4 showed normal cellularity with an increased number of Mks (arrows). Scale bars represent 50 μm. (C-F) Bone marrow smears (May-Grünwald-Giemsa staining) from members of families 8, 11, and 14. Representative examples of small, dystrophic Mks with hypolobulated nuclei and a small amount of mature eosinophilic cytoplasm. Typical micromegakaryocytes (F) were also observed. Scale bars represent 10 μm. Images were acquired as described in Figure 1 legend using a 20×/0.50 Plan Neofluar objective (panels A-B) and a 63×/1.25 Plan Neofluar oil-immersion objective (panels C-F) from Carl Zeiss.
Platelet flow cytometry
Flow cytometric evaluation of platelet GPs was performed in 33 patients from 15 families. Components of the GPIb/IX/V and GPIIb/IIIa complexes were similar in patients and controls, whereas GPIa was less than 80% of an appropriate control with the same ITGA2 genotype in 19 subjects from 14 families (data not shown). As for α-granule deficiency, GPIa was variably expressed in patients of the same family.
Platelet aggregation
Because of the low platelet count, in vitro platelet aggregation was evaluated in only 22 patients from 12 families. No consistent defect in the platelet response to any dose of collagen, ADP, or ristocetin was observed (data not shown).
Serum TPO
Twenty-six of 38 examined patients had serum TPO levels higher than normal range, with a mean TPO concentration 7 times higher in THC2 patients than in control (Table 2). Mean TPO level of THC2 patients was 2.9 times higher than that measured in 37 patients with ITP (38.3 ± 46.0 pg/mL). Because platelet count of ITP patients (51.7 ± 32.6 × 109/L) was comparable with those of THC2 patients, differences in TPO levels are expected to correlate with Mk mass (“Discussion”).
Discussion
THC2 has long been considered an exceedingly rare form of inherited thrombocytopenia in that only 2 families with this diagnosis were known.8,9 However, we recently identified mutations in the 5′-UTR of ANKRD26 in 9 THC2 pedigrees,12 and in the present paper we describe 11 additional families, all of them with mutations affecting a short stretch of 22 nucleotides in the same 5′-UTR region. By pooling the data from our previous work and those of the present study, 21 of the 125 families in our case series that remained without a definite diagnosis in the last 10 years actually had ANKRD26 mutations. To have an idea about the relative frequency of THC2, our database of 210 cases of inherited thrombocytopenias contains, in addition to 21 pedigrees with THC2, 37 families with monoallelic, dominant Bernard-Soulier syndrome resulting from Bolzano mutation, 10 with the classic biallelic, recessive form of Bernard-Soulier, 22 with MYH9-related disease, and a few cases of other very rare diseases. Thus, at least in Italy, THC2 represents one of the less rare forms of inherited thrombocytopenia. However, we think that this disorder is present worldwide because 4 of our families were from Spain, Argentina, United States, and Senegal.
The case series of 78 affected family members allowed us to define the clinical picture of THC2. The disorder is transmitted as an autosomal dominant trait in all families with almost complete penetrance, having only one subject with an ANKRD26 mutation normal platelet count. The degree of thrombocytopenia was variable, and repeated observations revealed that platelet count was variable also in the same subjects. Indeed, we detected transient increases in platelet concentration on 150 × 109/L in 4 patients, in all cases during inflammatory events. One possible explanation for this phenomenon may be that the increase in TPO levels that often occurs in reactive conditions17 benefitted thrombocytopenia by increasing platelet production. The recent demonstration that a TPO mimetic drug, eltrombopag, increased platelet count in patients with MYH9-related disease3 further supports this hypothesis and also offers hope that TPO mimetics may improve thrombocytopenia in THC2.
As the platelet count, also the severity of bleeding diathesis was variable, ranging from severe to nil. Although life-threatening events were reported, we are unaware of any patient dying of hemorrhage.
An alarming finding in our study was the high percentage of patients who developed acute leukemia, in that we identified 7 subjects with myeloid or undefined forms. Moreover, we noticed another 2 relatives of patients with ANKRD26 mutations who died of acute leukemia, but we were unable to clarify whether they were affected by THC2. Considering only subjects with certain THC2, the prevalence of acute leukemia was 167 of 100 000 (95% confidence interval, 67 to 345 of 100 000), which is much higher than in the general population. Indeed, the prevalence of acute leukemia has been estimated at 3.4 to 6.6 of 100 000, depending on race and sex (National Cancer Institute, www.seer.cancer.gov/statistics). A few THC2 patients also had chronic myelogenous or lymphocytic leukemias, or myelodysplastic syndrome. Two observations from the literature seem to suggest a possible connection between ANKRD26 and leukemia or, more in general, cancer. One somatic mutation in the coding region of ANKRD26 was described in one patient with acute myeloid leukemia,18 and a mouse model indicated that the tumor suppressor RARRES1 regulates Ankrd26.19 However, we are far from concluding that ANKRD26 mutations predispose to acute leukemia or to any other malignancy because the number of investigated patients is still too low. Moreover, the observation that acute leukemia affected only 4 of 21 families argues against this hypothesis. Anyway, we think that this matter deserves further study and that future descriptions of new THC2 patients should include an accurate family history about cancer. Clarifying this point may also be important in the light of the aforementioned potential benefit of treatments with TPO mimetic drugs, which should be used with caution if it is demonstrated that ANKRD26 mutations facilitate the onset of leukemia.
Concerning diagnosis, the typical patient with mutations in the 5′-UTR of ANKRD26 had moderate thrombocytopenia with normal-sized platelets, reduction of platelet α-granules, reduced platelet GPIa, normal platelet aggregation, and increased serum TPO levels. However, several exceptions have been observed, and we suggest that the most constant characteristic of our patients was that the size of their platelets was not enlarged. This feature is very useful for diagnostic purposes, in that the absence of platelet macrocytosis distinguishes THC2 from the majority of other inherited thrombocytopenias.
The observation that platelets from several patients had defective GPIa surface expression and reduced α-granule content deserves comment because, a few years ago, we described 2 families with autosomal dominant thrombocytopenia, normal platelet size, defective platelet expression of GPIa, and reduced platelet α-granules.15 Their clinical and laboratory picture, therefore, was indistinguishable from those of THC2, and we suspect that “autosomal dominant thrombocytopenia with reduced expression of glycoprotein Ia” and THC2 are the same disorder. However, we were unable to confirm this hypothesis because no affected member of the 2 previous families was available for genetic analysis.
Although the aim of our study was to identify the clinical and laboratory picture of THC2, our data on TPO levels and bone marrow examination in 4 patients allow us to speculate on the pathogenesis of thrombocytopenia in THC2 patients. TPO levels in blood are primarily regulated by platelets and Mks, which internalize and degrade TPO,20,21 and TPO levels are therefore inversely related to total Mk and platelet mass. The mean TPO value in THC2 patients was increased 7-fold compared with controls, indicating that the platelet-Mk mass was reduced. Interestingly, TPO levels in THC2 patients were 2.9 times higher with respect to a case series of 56 patients with ITP that had a completely superimposable platelet count. Considering that subjects with congenital amegakaryocytic thrombocytopenia have TPO levels more than 200 times higher than controls,22 we have to conclude that Mks were well represented in THC2, but to a lesser extent than in ITP, in which the Mk mass is typically expanded and the proportion of very large cells is increased. Therefore, the TPO values of THC2 subjects are consistent with the results of bone marrow examination, which revealed that the number of Mks was increased but also found dysmegakaryopoietic phenomena, such as micromegakaryocytes and Mks with a single nucleus and/or delayed maturation. Quite similar Mk defects were described in the Italian and American THC2 families reported 10 years earlier.8,9 Altogether, these data suggest that ANKRD26 mutations affect Mk maturation.
In conclusion, THC2 resulting from ANKRD26 mutations emerged from our study as one of the most frequent forms of inherited thrombocytopenias. Therefore, this diagnosis has to be considered in differential diagnosis of all patients with autosomal dominant forms of thrombocytopenia without platelet macrocytosis. Further investigation is required to ascertain whether the high prevalence of leukemia we observed derived from ANKRD26 mutations or occurred by chance.
An Inside Blood analysis of this article appears at the front of this issue.
The publication costs of this article were defrayed in part by page charge payment. Therefore, and solely to indicate this fact, this article is hereby marked “advertisement” in accordance with 18 USC section 1734.
Acknowledgments
The authors thank all patients and their families for participating in the project and Dr Concepción Boqué, Hospital de Bellvitge (Barcelona, Spain) for her collaboration in the clinical study of one family.
This work was supported by the Comitato Telethon Fondazione Onlus (grant GGP10089), the Istituto di Ricovero e Cura a Carattere Scientifico Burlo Garofolo (grant Ricerca Corrente 39/09), the Italian Istituto Superiore di Sanità (Italian/USA Grant on Rare Diseases), and the Francesco Fede Department of the Second University of Naples (Grant on Normal and Pathologic Hematopoiesis).
Authorship
Contribution: P.N., S.P., M.S., A.S., and C.L.B. designed the research, interpreted results, and wrote the manuscript; N.P.-M., G.L., F.S., A.P., S.S., M.Z., and L.D.N. acquired clinical data; C.G., D.D.R., F.M., E.C., F.P., M.C., G.A., C.M., and T.P. performed laboratory investigation; C.K. performed statistical analysis; and all authors had access to primary clinical trial data and approved the final manuscript.
Conflict-of-interest disclosure: The authors declare no competing financial interests.
Correspondence: Carlo L. Balduini, Clinica Medica III, Istituto di Ricovero e Cura a Carattere Scientifico Policlinico San Matteo-Università di Pavia, Piazzale Golgi, 27100 Pavia, Italy; e-mail: c.balduini@smatteo.pv.it.